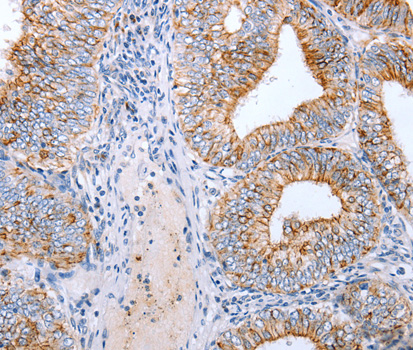
A2946: image 2

For quotations, please use our online quotation form, and you may also contact us by
sales@neoscientific.com
+1-888.733.6849
+1-617.299.7367 (Int’l)
+1-888.733.6849
+1-617.299.7367 (Int’l)
| Reactivity | Human Mouse Rat |
| Tested applications | WB IHC |
| Recommended Dilution | WB 1:500 - 1:2000 IHC 1:100 - 1:200 |
| Calculated MW | 23kDa |
| Observed MW | Refer to Figures |
| Immunogen | Recombinant protein of human CLDN3 |
| Storage Buffer | Store at -20℃. Avoid freeze / thaw cycles. Buffer: PBS with 0.02% sodium azide, 50% glycerol, pH7.3. |
| Synonym | RVP1;HRVP1;C7orf1;CPE-R2;CPETR2; |

Western blot analysis of extracts of HT-29 cell line, using CLDN3 antibody.
Immunohistochemistry of paraffin-embedded mouse stomach using CLDN3 antibody.

Immunohistochemistry of paraffin-embedded human colon using CLDN3 antibody.

Immunohistochemistry of paraffin-embedded human stomach using CLDN3 antibody.

Immunohistochemistry of paraffin-embedded mouse liver using CLDN3 antibody.
Tight junctions represent one mode of cell-to-cell adhesion in epithelial or endothelial cell sheets, forming continuous seals around cells and serving as a physical barrier to prevent solutes and water from passing freely through the paracellular space. These junctions are comprised of sets of continuous networking strands in the outwardly facing cytoplasmic leaflet, with complementary grooves in the inwardly facing extracytoplasmic leaflet. The protein encoded by this intronless gene, a member of the claudin family, is an integral membrane protein and a component of tight junction strands. It is also a low-affinity receptor for Clostridium perfringens enterotoxin, and shares aa sequence similarity with a putative apoptosis-related protein found in rat.
N/A